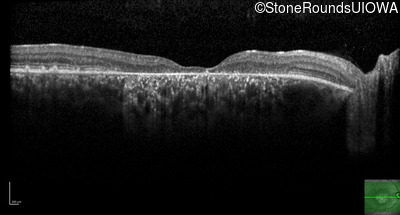
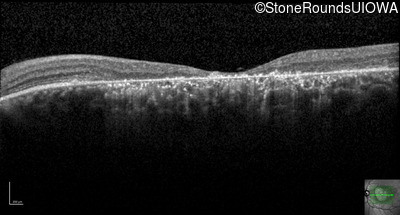

Case
SR1827
Student Mode
AR Stargardt Disease (IIA)
Female
Female
Hidden
SR1827
Student Mode
AR Stargardt Disease (IIA)
Female
Female
History
This 35 year old woman first started holding her reading material closer than normal when she was 7 years old.
Diagnosis & molecular findings
| Disease | Gene | Allele 1 variant(s) | Allele 2 variant(s) | Inheritance mode |
|---|---|---|---|---|
| AR Stargardt Disease | ABCA4 | Val1681 del15gctGTGGTTGCCATCTGC | Gly1961Glu GGA>GAA | AR |
Disease:
Gene:
Allele 1:
Val1681 del15gctGTGGTTGCCATCTGC
Allele 2:
Gly1961Glu GGA>GAA
Inheritance:
AR